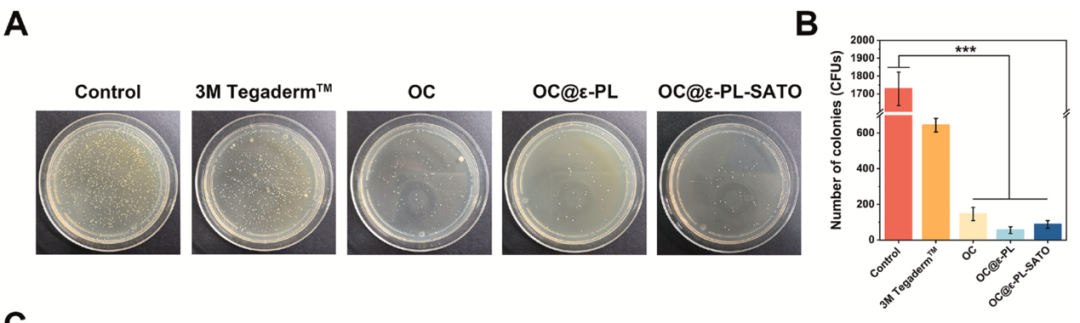

《Biomaterials》:感染创面修复新利器

背景
感染创面修复面临多重挑战:细菌感染引发的过度炎症、巨噬细胞 M1/M2 表型失衡、血管新生受阻,传统敷料往往难以兼顾抗菌、抗炎与促愈合功能。硫化氢(H₂S)气体疗法虽能调控炎症、促进组织修复,但存在释放失控、生物利用度低等问题,限制了临床应用。
近日,西北工业大学团队在《Biomaterials》发表创新研究,开发出一种多功能可注射水凝胶 OC@ε-PL-SATO。该材料通过 “持续 H₂S 释放 + 抗菌 + 免疫调控” 协同作用,在感染创面模型中实现高效修复,其核心机制是通过干扰 PI3K/Akt 通路促进巨噬细胞 M2 极化,为感染创面治疗提供了全新的纳米治疗方案。

通过两步法实现 H₂S 的稳定负载与可控释放
H₂S 供体优化:将疏水性 H₂S 供体 SATO 通过酰胺缩合反应接枝到亲水性 ε- 聚赖氨酸(ε-PL)上,合成 ε-PL-SATO,显著提升水溶性与 H₂S 释放效率。

双组分水凝胶制备:采用双管注射器设计,A 管含羧甲基壳聚糖(CMCS)与 ε-PL-SATO,B 管含氧化透明质酸(OHA)与引发剂 N - 乙酰半胱氨酸(NAC),混合后通过席夫碱反应快速成胶(<30s)。

关键特性适配:水凝胶具有疏松多孔结构,溶胀率达 20-23,14 天内可生物降解,同时具备剪切变稀与自修复能力,适配不规则创面。



水凝胶实现 H₂S 的长效可控释放,且生物相容性优异
缓释特性:通过 WSP-5 荧光探针和 H₂S 检测试剂盒验证,水凝胶可持续释放 H₂S 达 48h,6h 时释放峰值约 7μM,处于生物安全浓度范围。

细胞与血液相容性:对 L929 成纤维细胞和 RAW264.7 巨噬细胞无细胞毒性,活 / 死染色显示绿色荧光占比极高。溶血率 < 4%,红细胞形态保持完整,符合生物医用标准。


促细胞迁移:划痕实验显示,水凝胶提取物处理 48h 后,L929 细胞迁移率接近 100%,显著高于对照组。


水凝胶通过成分协同实现强效抗菌
广谱抗菌活性:对创面常见致病菌大肠杆菌(E. coli)和金黄色葡萄球菌(S. aureus)均有显著抑制作用,24h 后细菌菌落数大幅减少。

抗菌机制明确:CMCS 与 ε-PL 的阳离子成分可破坏细菌细胞膜,FESEM 观察到细菌形态扭曲、破裂。

生物膜抑制:能有效阻止细菌生物膜形成,减少感染复发风险。



核心机制:H₂S 介导 PI3K/Akt 通路调控巨噬细胞极化
水凝胶释放的 H₂S 可显著推动巨噬细胞 M2 极化
表型转换:流式细胞术显示,OC@ε-PL-SATO 组 CD206⁺(M2 标志物)巨噬细胞比例显著高于 OC 组和 OC@ε-PL 组,接近 IL-4 阳性对照组。

细胞因子平衡:ELISA 检测证实,水凝胶处理后,促炎因子 TNF-α、IL-1β 分泌减少,抗炎因子 IL-10、TGF-β 水平升高,实现炎症微环境重构。

通过转录组测序与 Western blot 揭示核心机制
差异基因富集:RNA-seq 显示,OC@ε-PL-SATO 处理后,巨噬细胞中 1194 个基因上调、1098 个基因下调,显著富集于 PI3K/Akt、NF-κB 等炎症相关通路。

通路调控验证:Western blot 证实,水凝胶释放的 H₂S 可抑制 LPS 诱导的 PI3K 和 Akt 磷酸化,同时降低 NF-κB 表达,进而抑制 M1 极化、促进 M2 表型转换。

在金黄色葡萄球菌感染的大鼠全层皮肤缺损模型中,OC@ε-PL-SATO 水凝胶表现出显著修复优势
快速止血与抗菌:大鼠尾断出血模型显示,水凝胶止血时间(~110s)显著短于纱布和 3M 敷料组,出血量减少 50% 以上。创面细菌计数显示,3 天后 OC@ε-PL-SATO 组细菌载量仅 55 CFU/mL,远低于对照组。

加速创面闭合:14 天内 OC@ε-PL-SATO 组创面闭合率达 99%,显著高于 OC 组(85%)和 3M 敷料组(88%)。

组织再生与血管新生:H&E 和 Masson 染色显示,水凝胶组表皮完整、胶原沉积致密,毛囊数量显著增加。免疫组化证实,CD31⁺血管面积和 TGF-β 表达量显著高于对照组,表明血管新生增强。


炎症微环境改善:免疫荧光显示,创面 CD86⁺(M1 标志物)巨噬细胞比例降低,CD206⁺(M2 标志物)比例升高,炎症反应得到有效调控。


临床转化优势与价值
多功能集成:同时具备抗菌、持续 H₂S 释放、免疫调控、止血、促血管新生功能,一站式解决感染创面修复痛点;
使用便捷:可注射设计适配不规则创面,快速成胶能力避免移位,无需二次手术移除;
生物安全性高:原料为天然多糖(CMCS、OHA)与改性多肽,生物相容性优异,降解产物无毒性;
机制明确:通过 PI3K/Akt 通路调控巨噬细胞极化,为后续优化提供明确分子靶点。
总结
OC@ε-PL-SATO 水凝胶通过 “智能 H₂S 缓释 + 抗菌 + 免疫调控” 三重协同作用,成功解决了感染创面的核心修复难题。其创新点在于将疏水性 H₂S 供体亲水化改造,实现可控释放,同时通过干扰 PI3K/Akt 通路推动巨噬细胞 M2 极化,兼顾抗菌与促血管新生。该材料在感染创面模型中表现出高效修复效果,为临床感染创面(如糖尿病足、烧伤感染)治疗提供了全新的可注射敷料选择,具有广阔的转化前景。
关于赛箔生物
赛箔(上海)智能科技有限公司是一家专注于研发生物制造技术和组织工程产品的高新技术企业,成立于2021年2月。自主研发多种已经获得国家发明专利授权的生物3D打印技术和装备、生物材料、体外细胞和组织培养技术、组织处理和培养装置。基于核心技术开发多种器官组织模型和相应的检测评价服务,为基础研究、新药研发、精准医疗、再生医学等领域提供生物3D打印全产业链解决方案,实现了从设备到产品到服务的全面覆盖。
在肿瘤相关领域,赛箔与合作者共同研发基于生物3D打印技术构建的肿瘤微组织(PDT),涵盖十余个癌种,包括高发肿瘤、难治肿瘤、妇科肿瘤和儿童肿瘤,培养成功率超过了90%。通过近千例样本研究,证实PDT与患者组织具有高度一致的分子特征和药物敏感性,1-2周即可获得准确的药敏检测结果,为治疗赢取宝贵时间,并且可为新药研发企业提供药效评价、入组标准建立、适应症筛选等服务。在再生相关领域,赛箔已建立多种3D组织工程皮肤,包括表皮模型、全层皮肤模型、黑素皮肤模型等,并相应开发多种体外功效测试方法。

肺癌

宫颈癌

结直肠癌

卵巢癌

脑胶质瘤

神经母细胞瘤

黑色素皮肤模型

全层皮肤模型

表皮模型
